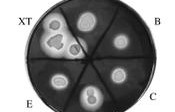

1.导论 1.1选题背景与研究意义 人民币国际化问题一直是全世界关注的焦点话题,尤其是在...
50
2025-08-02

一、研究意义 随着中国经济高速发展,重庆的经济也开始腾飞,自2014年以来,重庆市地区全年生产总值连...
46
2025-08-02

一、引 言 2011年,经国务院批准,在财政部、国家税务总局的联合下下发了营业税改征增值税试点的方案...
45
2025-08-02

一、选题背景及文献回顾 (一)选题背景 作为与8个国家接壤有着丰富矿产能源等资源的西北边陲地区,新疆...
42
2025-08-02

安全接种范文(精选11篇) 资料与方法 2013年10月-2014年8月选择我中心预防接种儿童234...
47
2025-08-02

肠球菌是条件致病菌,可导致人体多脏器的感染,不仅可引起尿路感染、皮肤软组织感染,还可引起危及生命的腹...
38
2025-08-02

安全工作春节讲话(精选8篇) 关于春节期间安全生产工作的讲话 同志们: 经我镇政府研究决定,在元旦春...
44
2025-08-02

第一章 导论 1.1 研究背景 1.1.1 我国旅游营销概况 自从改革开放以来,随着...
65
2025-08-02

1.引言 1.1研究背景及意义 新中国成立以后,在经历过一个漫长的历史潜伏期,终于迎来了...
46
2025-08-02

1引言 1.1选题动机 中国经济体制改革后,经济快速发展已经达到了前所未有的水平。市场经济的强烈影响...
50
2025-08-02

安全监理专项实施细则(精选6篇) 塔吊专项安全监理细则 聚丰国际大厦 塔吊安全监理实施细则 编制:...
41
2025-08-02

在互联网创新2.0的时代下,人们创造性的提出了“互联网+”的行动理念。近年来,“互联网+财务管理”也...
40
2025-08-02

第一章 序言:新西兰奥克兰大学的两名教授开发了R语言,其中它可以用来进行数据处理、计算以及制图的免费...
44
2025-08-02

一、引言 全球经济危机的震荡之后,网络技术不断发展共享经济成为了过度消费的新型解决方案。互联网+背景...
55
2025-08-02
1 引言 淀粉酶是水解淀粉和糖原酶类的总称[1],是一种能使糖原水解和催化淀粉转化为葡萄糖、...
45
2025-08-02

第一章 绪论 1.1研究背景 会展产业,是信息经济时代新兴的第三产业,具有巨大的经济效益...
67
2025-08-02

引言 在这个飞速发展的社会,信息技术的更新换代日益加快,信息大爆炸时代的我们无时不刻不被包围...
65
2025-08-02